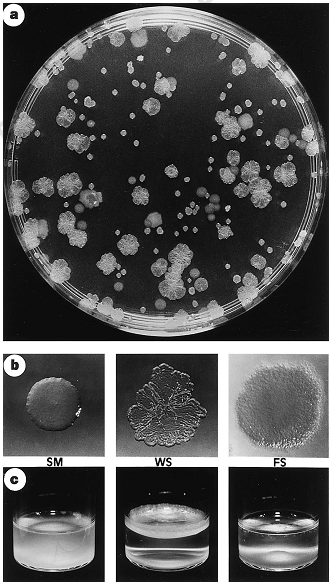

আগের লেখায় বলেছিলাম, ব্যাক্টেরিয়া-ভাইরাসের বিবর্তন আজকাল গোঁরা সৃষ্টিবাদীরাও স্বীকার না করে পারে না। তখন থেকেই মনে হচ্ছিলো এ ব্যাপারে কিছু নিদর্শন হাজির করা যাক। সে উদ্দেশ্যেই এই নোট। শুরু করবার আগে সৃষ্টিবাদীদের একটা দাবিকে নিয়ে কিছু কথা বলা যাক।
সৃষ্টিবাদীদের একটা বহুল উচ্চারিত দাবি হচ্ছে – পরিব্যপ্তির* মাধ্যমে তথ্য বাড়ে না, বরং কেবল হ্রাসই পায় এবং সব মিউটেশনই জীবের জন্য ক্ষতিকর। ‘ইনফরমেশন থিররি’র মারপ্যাঁচে বিবর্তনবাদকে কুপকাত করার এ মিশনে একেবারে সামনের কাতারে আছে উইলিয়াম ডেম্ব্স্কি, ওয়ার্নার গিট এবং লি স্পেটনারদের মতো কিছু হেভিওয়েট বুদ্ধিজীবী। সোজা কথায় তাদের বক্তব্য হচ্ছে, মানুষ ও অন্যান্য জীবের গঠন এতটাই জটিল যে তা পরিব্যপ্তির (mutation) মাধ্যমে অর্জন করা অসম্ভব।১
বিবর্তনবাদের প্রেক্ষাপটে ইনফর্মেশন থিওরি সম্বন্ধে এবার কিছু বলা প্রয়োজন। জীবের জেনেটিক কোডকে যদি একটি অর্থবহ বাক্যের সঙ্গে তুলনা করা যায়, তাহলে বাক্যের মধ্যকার কোন শব্দের দুটি বর্ণ অদল বদল করে দিলে যেমন বাক্যের আর কোন অর্থ থাকে না, তেমনি মিউটেশনের ফলে জীবের জেনেটিক গঠন পরিবর্তিত হলে জীবটি কখনো সুস্থ ‘স্বাভাবিক’ হতে পারে না, হবে বিকৃত, অসুস্থ। উদাহরণঃ পারমানবিক তেজস্ক্রিয়তায় জন্মানো বিকলাঙ্গরা। আরেকটু ব্যাখ্যা করি। “রান্না করতে লাকড়ি প্রয়োজন” – এ বাক্যটিই ধরুন। এখানে ‘রান্না’, ‘করতে’, ‘লাকড়ি’, ‘প্রয়োজন’ ইত্যাদি শব্দগুলোকে ধরুন একেকটি অ্যামাইনো এসিড।** নির্দিষ্ট ক্রমে শব্দগুলোকে পরপর সাজালে যেভাবে একটি পূর্ণাঙ্গ অর্থবহ বাক্য পাবো, তেমনি সবগুলো এমাইনো এসিড নির্দিষ্ট ক্রমে যুক্ত হলেই একটি ‘কার্যকর’ প্রোটিন পাওয়া যাবে। কিন্তু মিউটেশনের মাধ্যমে যদি কোন একটি এমাইনো এসিড বদলে যায়, তাহলে প্রোটিনটিও বদলে যাবে, ঠিক যেমন ‘লাকড়ি’ বদলে ‘লাড়কি’ হয়ে গেলে বাক্যটির অর্থও বদলে যাবে। এভাবে মিউটেশনের মাধ্যমে কোন প্রোটিনের ‘অর্থ’ পরিবর্তিত হয়ে যাওয়ার মানে হচ্ছে ও আর আগের কাজটা করতে পারবে না। তবে বাস্তবে ব্যাপারটা মোটেও এরকম নয়।
সত্যি বলতে, বাক্য ও প্রোটিনের মধ্যে সাদৃশ্য খোঁজা আর মুরগির ডিম ও ঘোড়ার ডিমের মধ্যে মিল খোঁজার মধ্যে গুণগত কোন পার্থক্য নেই। মজার ব্যাপার হচ্ছে, সৃষ্টিবাদীদের যুক্তি দিয়েই তাদের দাবিকে খণ্ডন করা যায়। বাক্যের উদাহরণে ফিরে যাই। বাক্যের কোন একটি শব্দের বর্ণগুলো এলোমেলো হয়ে গেলে প্রচলিত অর্থে বাক্যটা তার যোগ্যতা হারাবে ঠিকই, তবে ওই ভুল শব্দটিকে নিয়েই বাক্যটির নতুন অর্থ হতে পারে। উদাহরণের বাক্যটিতে ‘লাকড়ি’র জায়গায় ‘লাড়কি’(মেয়ে) বসলেও কিন্তু একটা অর্থ তৈরি হচ্ছে। তেমনি কোন একটি প্রোটিন পরিবর্তিত হয়ে গেলে সেটি হয়ত তার আগেকার কাজটি করতে পারবে না, কিন্তু তাই বলে ভিন্ন কোন কাজের মাধ্যমে যে সে তার বাহক জীবের কোন উপকারে আসবে না এমনটি কিন্তু বলা যাবে না।
আবার, কোন ধ্বনি বা ধ্বনিসমষ্টি একটি নির্দিষ্ট ভাষায় কোন অর্থ প্রকাশ না করলেও অন্য ভাষায় কিন্তু সেটির অর্থ থাকতে পারে। যেমন- বাংলায় ‘লাকড়ি’ লিখতে গিয়ে ভুলে ‘লাড়কি’ লিখে ফেললেও হিন্দিতে কিন্তু এটার সুন্দর একটা অর্থ থেকে যায়। তাই এভাবে বাক্যের সঙ্গে প্রোটিনের তুলনা করাটা নিছক বালসুলভ সরলীকরণ ব্যাপার হয়ে যায়। কোন একটি প্রোটিনের আদৌ কোন ‘অর্থ’ আছে কি নেই, তা যাচাই করতে দেখা দরকার সেটি অন্যান্য অনু ও জৈব-অজৈব পদার্থের সঙ্গে কীভাবে মিথষ্ক্রিয়ায় অংশ নেয় এবং জীবের জীবনপ্রণালিতে কীরূপ প্রভাব ফেলে।
মিউটেশনের ফলে প্রোটিনের গঠনে যে পরিবর্তন আসে, সেটি সবসময়ই যে ক্ষতিকর হবে তা নয়। মিউটেশনের ফলাফল অবস্থা ও পরিবেশভেদে বিভিন্ন হতে পারে। অধিকাংশ মিউটেশনই নিরপেক্ষ। কিছু আছে ক্ষতিকর এবং কিছু আছে উপকারী। পরিব্যাপ্ত(mutant) ক্ষতিকর জিনগুলো সাধারনত তাদের প্রতিরূপ তৈরি করার আগেই প্রাকৃতিক নির্বাচনের মাধ্যমে বিলুপ্ত হয়ে যায়। কিন্তু উপকারী ও নিরপেক্ষগুলো টিকে যায় এবং জীবের প্রজননে তাদের সার্থকতার উপর নির্ভর করে জিনপুলে তাদের এলিল ফ্রিকোয়েন্সির পরিবর্তন হতে থাকে। আবার প্রোটিনের গঠনে কোন জিনগত পরিবর্তন উপকারী না অপকারী হবে, সেটিও নির্ভর করে জীবের পারিপার্শ্বিক পরিবেশের উপর। এক পরিবেশে একটি মিউটেশন কোন জীবের জন্য ক্ষতিকর বিবেচিত হতে পারে। কিন্তু সেই একই মিউটেশন অন্য পরিবেশে সেই একই জীবের বেঁচে থাকার একমাত্র সহায় হওয়াও অসম্ভব নয়।
বলাই বাহুল্য যে, সৃষ্টিবাদীদের ইনফর্মেশন থিওরি বৈজ্ঞানিক মহলে অনেক আগেই পরিত্যক্ত হয়েছে। নতুন বৈশিষ্ট্যের উৎপত্তি অসম্ভব তো নয়ই, বরং এটি প্রকৃতির এক নিত্যনৈমিত্তিক ঘটনা। মিউটেশন ও জিন ডুপ্লিকেশনের মাধ্যমে অহরহ নতুন বৈশিষ্ট্য তৈরি হচ্ছে। সম্পূর্ণ নতুন এবং স্বতন্ত্র বৈশিষ্ট্যের উদ্ভবের অজস্র প্রমাণ রয়েছে আশপাশে। উদাহরণ হিসেবে নাইলনভোজী ব্যাক্টেরিয়ার (nylon eating bacteria) কথা বলা যায় যাদের মধ্যে সাম্প্রতিক সময়ে সম্পূর্ণ নতুন এক এনজাইমের উপস্থিতি পরিলক্ষিত হয়েছে যার সাহায্যে এরা নাইলন বর্জ্য পরিপাক করতে সক্ষম। তাদের ডিএনএ অনুক্রমে ফ্রেইম শিফ্ট মিউটেশন (frame shift mutation; ডিএনএ অনুক্রমের কোন স্থানে এক বা একাধিক বেইসের সংযুক্তি বা অপসারণের মাধ্যমে ঘটা মিউটেশন) সংঘটনের ফলে তারা এই এনজাইম তৈরির ক্ষমতা লাভ করেছে। (Negoro et al. 1994; Thomas n.d.; Thwaites 1985) স্বভাবতই ব্যাক্টেরিয়াগুলোর আদি পূর্বপুরুষদের মাঝে এধরনের কোন এনজাইমের অস্তিত্ব খুঁজে পাওয়ার প্রশ্ন আসে না, কেননা ১৯৩৫ সালের আগে নাইলন উদ্ভাবিতই হয়নি। এটি নিশ্চিতভাবে মিউটেশনের মাধ্যমে উদ্ভূত নতুন তথ্য সংযোজনের প্রমাণ বহন করে, তা-ই নয় কি? ভাবুন এবার, মিউটেশনটা যদি ১৯৩৫ এর আগে হতো, তাহলে সেটা কোন উপকারে তো আসতোই না, বরঞ্চ ব্যাক্টেরিয়াগুলোর জন্য প্রাণনাশক হতো। মিউটেশনের আগে এনজাইমটি ব্যাক্টেরিয়ার কার্বোহাইড্রেট হজমে ব্যবহৃত হতো, সুতরাং, নাইলন উভাবনের আগে এমন মিউটেশন ঘটলে ব্যাক্টেরিয়াগুলো না খেতে পেয়েই মারা যেতো।
এমন আরো অসংখ্য দালিলিক দৃষ্টান্ত দেয়া যায়। এক পাবমেড সার্চেই জিন ডুপ্লিকেশনের ৩০০০টির উপর রেফারেন্স পাওয়া যায়। নিচে মিউটেশন ও জিন ডুপ্লিকেশনের এমন কয়েকটি দৃষ্টান্ত উপস্থাপন করা হলো যেখানে মিউটেশনের ফলে তথ্য না হারিয়ে বরং সংযুক্ত হচ্ছেঃ২
- RNASE1 নামের জিনটি একটি এনজাইম প্রস্তুতির জন্য দায়ী। জিনটিতে ডুপ্লিকেশন ঘটে এবং লেঙ্গুর বানরদের মধ্যে এর একটি কপি পরিব্যপ্ত হয়ে তৈরি করে RNASE1B । ক্ষুদ্রান্ত্রের অম্লীয় পরিবেশে এটি অপেক্ষাকৃত ভালোভাবে কাজ করে। (Zhang et al. 2002)
- Pseudomonas fluorescens ব্যাক্টেরিয়ার কিছু স্ট্রেইন তিনটি ভিন্ন স্তরবিশিষ্ট একটি পাত্রে রাখা হয়। প্রতিটি স্তরের পরিবেশকে অক্সিজেনের ঘনত্বের তারতম্যের ভিত্তিতে পৃথক রাখা হয়। এক সপ্তাহের মধ্যেই দেখা যায় প্রথমোক্ত ব্যাক্টেরিয়া থেকে আরো দুই ধরনের ব্যাক্টেরিয়া উৎপন্ন হয়েছে যারা পাত্রের উপরের ও নিচের স্তর দখল করে ফেলে (আদি প্রকরণটি পাত্রের মাঝের অংশে অবস্থান করে)। উৎপন্ন দুটি প্রকরণই জিনগতভাবে তাদের মাতৃপ্রকরণ থেকে ভিন্ন। (Paul Rainey et al. 1998) গবেষণাপত্রটি পাবেন এখানে।
চিত্র ১ – Pseudomonas fluorescens ব্যাক্টেরিয়ার ফিনোটাইপিক পরিবর্তনঃ (a) ৭দিন পর ব্যাক্টেরিয়ার ফিনোটাইপিক প্রকরণগুলো স্পষ্ট হয়ে উঠেছে। (b) প্রকরণগুলোকে প্রধাণত তিনটি শ্রেণীতে পৃথক করা যায়ঃ আদি মসৃণ প্রকরণ (SM) এবং নতুন কুঞ্চিত (WS) ও ঘোলাটে প্রকরণ (FS)। (c) ব্যাক্টেরিয়াগুলোর স্ব স্ব পাত্র
চিত্র ১ – Pseudomonas fluorescens ব্যাক্টেরিয়ার ফিনোটাইপিক পরিবর্তনঃ (a) ৭দিন পর ব্যাক্টেরিয়ার ফিনোটাইপিক প্রকরণগুলো স্পষ্ট হয়ে উঠেছে। (b) প্রকরণগুলোকে প্রধাণত তিনটি শ্রেণীতে পৃথক করা যায়ঃ আদি মসৃণ প্রকরণ (SM) এবং নতুন কুঞ্চিত (WS) ও ঘোলাটে প্রকরণ (FS)। (c) ব্যাক্টেরিয়াগুলোর স্ব স্ব পাত্র
- খুব অল্প পরিমাণ চিনিপূর্ণ একটি মাধ্যমে ইস্ট রাখা হয়েছিল। ৪৫০ প্রজন্ম পর হেক্সোস ট্রান্সপোর্ট জিনে (hexose transport genes) ডুপ্লিকেশন ঘটে এবং সেই ডুপ্লিকেইটেড ভার্শনের কয়েকটিতে আবারও মিউটেশন ঘটে। (Brown et al. 1998)
- গ্লুকোজপূর্ণ ১২টি ভিন্ন ফ্লাস্কে Escherichia coli ব্যাক্টেরিয়ার কিছু জিনগতভাবে সদৃশ (identical) স্ট্রেইন রেখে প্রতিটি পাত্রে একই পরিমাণ গ্লুকোজ সরবারহ করা হয়। পরবর্তী আঠারো বছরে প্রায় ৪০,০০০ প্রজন্ম অতিবাহিত হলে দেখা যায় কিছু স্ট্রেইন আদিগুলোর তুলনায় ৭০% বেশি বৃদ্ধি পায়। পরীক্ষায় পরবর্তীতে নয়টি পৃথক জিন শনাক্ত করা হয় যেগুলোতে মিউটেশনের ফলেই ব্যাক্টেরিয়াগুলোর এ ক্ষমতা অর্জিত হয়েছে (Lenski et al. 1998)। বলে রাখা ভালো, এক্সপেরিমেন্টটা এখনো চলছে।
- Escherichia coli ব্যাক্টেরিয়া থেকে ল্যাকটোজ হজমকারী এনজাইম উৎপন্নকারী একটি জিন অপসারণ করে ল্যাকটোজপূর্ণ পাত্রে রাখা হয়। প্রথমদিকে এদের বৃদ্ধি বন্ধ হয়ে গেলেও কিছু পরেই দেখা যায় হারানো এনজাইমটির কাজ অন্য আরেকটি এনজাইম দুর্বলভাবে সম্পাদন করছে, যেটি আগে ল্যাকটোজ হজম করতে অক্ষম ছিল। পরবর্তীতে পর্যায়ক্রমে আরো দুটি মিউটেশন ঘটে। একটিতে এনজাইমের পরিমাণ বৃদ্ধি পায় এবং অন্য মিউটেশনটি ঘটে ভিন্ন একটি জিনে যেটি পরিবেশ থেকে ল্যাকটোজ গ্রহণ করতে ব্যাক্টেরিয়াকে আরো সক্ষমতা প্রদান করে। (Barry Hall et al. 1976)
চিত্র ২- হোমিওটিক মিউটেশনের (homeotic mutation) মাধ্যমে ডেভেলপমেন্ট পাথওয়ে পরিবর্তনের ফলে ড্রসোফিলার ফিনোটাইপিক পরিবর্তনঃ (A) বন্য Drosophila melanogaster প্রজাতির একটি মাছির মাথার সম্মুখদৃশ্য। এতে স্বাভাবিক এন্টেনা ও অন্যান্য মুখোপাঙ্গ দেখা যাচ্ছে। (B) Antennapedia মিউটেশনে পরিবর্তিত ফিনোটাইপ নিয়ে জন্মানো মাছির মাথার সম্মুখদৃশ্য। মিউটেশনের ফলে এর যেখানে এন্টেনা থাকবার কথা, সেখানে সে পা নিয়ে জন্মেছে। Antennapedia হচ্ছে Hox জিনকমপ্লেক্সের অন্তর্গত একটি জিন। Hox জিনগুলোই নিয়ন্ত্রণ করে কোন অঙ্গ-প্রত্যঙ্গ কোথায় অবস্থান করবে। Antennapedia জিনের কাজ হচ্ছে এন্টেনার অবস্থান নির্ধারণ করা। কিন্তু জিনটিতে মিউটেশনের ফলে এন্টেনার জায়গায় স্থলাভিষিক্ত হয়েছে পা!
এমন আরো অসংখ্য উপাত্ত হাজির করা যায় যা সৃষ্টিবাদীদের এ দাবিকে মিথ্যা প্রমাণ করতে পারে। মিউটেশন ও জিন ডুপ্লিকেশনের মাধ্যমে প্রকৃতিতে প্রতিনিয়ত নতুন তথ্যের উন্মেষ ঘটছে, বিজ্ঞানীরা যার অতি ক্ষুদ্র একটি ভগ্নাংশমাত্র লিপিবদ্ধ করেছেন। এত এত সাক্ষ্যপ্রমাণ থাকা সত্ত্বেও যদি কেউ বলে মিউটেশনের ফলে তথ্য হ্রাস পায়, তাহলে তার মুখে মুতে দেয়া ছাড়া আর কী করার থাকে?
রেফারেন্সঃ
১. Gitt, Werner (1996). Information, science and biology. Answers in Genesis
২. Talk Origins
পাদটীকাঃ
* ডিএনএ’র প্রতিলিপি তৈরির সময় কখনো কখনো ভুল (error) হয়, ফলে নিউক্লিওটাইড সিকোয়েন্স সামান্য বদলে যেতে পারে। এটাই মিউটেশন। এর ফলে যে জিনে মিউটেশন ঘটে, সেটা যে বৈশিষ্ট্যের জন্য দায়ী, সেটাও বদলে যায়। বিবর্তন ঘটার পূর্বশর্ত হচ্ছে পপুলেশনের জীবগুলোর মধ্যে ভ্যারিয়েশন থাকবে। আর ভ্যারিয়েশন তৈরির অন্যতম প্রধান নিয়ামক হচ্ছে এই মিউটেশন বা পরিব্যপ্তি। ইন্টারের বায়োলজি বই বুঝে পড়ে এসেছেন যারা, তারা জেনে থাকবেন। 😛
** অ্যামাইনো এসিড হচ্ছে প্রোটিনের গাঠনিক একক। অনেকগুলো অ্যামাইনো অ্যাসিড মিলে তৈরি করে একেকটি প্রোটিন যেগুলো জীবের বিভিন্ন বৈশিষ্ট্যের জন্য দায়ী। যেমন, কালো ত্বকের জন্য দায়ী একটি প্রোটিনের নাম মেলানিন। মেলানিন বেড়ে গেলে ত্বক কালো হয়ে যায়।

Leave a comment